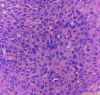

An Immunohistochemical Study on Ki-67 Expression in Squamous Cell Carcinomas of Cervix With Clinicopathological Correlation
- PMID: 36843724
- PMCID: PMC9949686
- DOI: 10.7759/cureus.34155
An Immunohistochemical Study on Ki-67 Expression in Squamous Cell Carcinomas of Cervix With Clinicopathological Correlation
Abstract
Background Cervical carcinoma is one of the most prevalent cancers affecting women worldwide. Studies on Ki-67 expression in cervical lesions had focused mainly on the intraepithelial lesions of the cervix and not much on invasive carcinomas. The few studies published so far on Ki-67 expression in invasive cervical carcinomas have shown inconsistent results on the association of Ki-67 with various clinicopathological prognostic factors. Aims and objectives To assess Ki-67 expression in cervical carcinomas and to compare it with various clinicopathological prognostic factors. Materials and methods Fifty cases of invasive squamous cell carcinoma (SCC) were included in the study. Histological patterns and grades were identified and noted in these cases after microscopic examination of the histological sections. Immunohistochemical (IHC) staining with anti-Ki-67 was done and scored from 1+ to 3+. This score was compared with clinicopathological prognostic factors like clinical stage, histological pattern, and grade. Result Among the 50 cases of SCC, 41 showed keratinizing pattern (82%) and nine showed non-keratinizing pattern (18%). Four were in stage I, 25 were in stage II, and 21 were in stage III. Overall, 34 (68%) cases had Ki-67 score 3+, 11 (22%) had Ki-67 score 2+, and five (10%) had Ki-67 score 1+. Ki-67 score of 3+ was the most common score in keratinizing SCC (75.6%), poorly differentiated carcinomas (76.2%), and stage III cases (81%). Conclusion We observed statistically significant correlation of Ki-67 expression with higher clinical stage, keratinizing tumours, and poorly differentiated tumours (p<0.05) indirectly implying the poor prognostic significance of this marker.
Keywords: cervical carcinoma; clinical stage; histological grade; keratinizing squamous cell carcinoma; ki-67; squamous cell carcinoma.
Copyright © 2023, R et al.
Conflict of interest statement
The authors have declared that no competing interests exist.
Figures

References
-
- Global cancer statistics 2020: GLOBOCAN estimates of incidence and mortality worldwide for 36 cancers in 185 countries. Sung H, Ferlay J, Siegel RL, Laversanne M, Soerjomataram I, Jemal A, Bray F. https://doi.org/10.3322/caac.21660. CA Cancer J Clin. 2021;71:209–249. - PubMed
-
- Epithelial-mesenchymal transition in cervical carcinoma. Lee MY, Shen MR. https://www.ncbi.nlm.nih.gov/pmc/articles/PMC3276374/ Am J Transl Res. 2012;4:1–13. - PMC - PubMed
-
- MIB-1 and PCNA immunostaining as a diagnostic adjunct to cervical Pap smear. Goel MM, Mehrotra A, Singh U, Gupta HP, Misra JS. https://doi.org/10.1002/dc.20218. Diagn Cytopathol. 2005;33:15–19. - PubMed
-
- MIB1, a promising marker for the classification of cervical intraepithelial neoplasia. Bulten J, van der Laak JA, Gemmink JH, Pahlplatz MM, de Wilde PC, Hanselaar AG. https://doi.org/10.1002/(SICI)1096-9896(199603)178:3%3C268::AID-PATH482%.... J Pathol. 1996;178:268–273. - PubMed
LinkOut - more resources
Full Text Sources
Research Materials